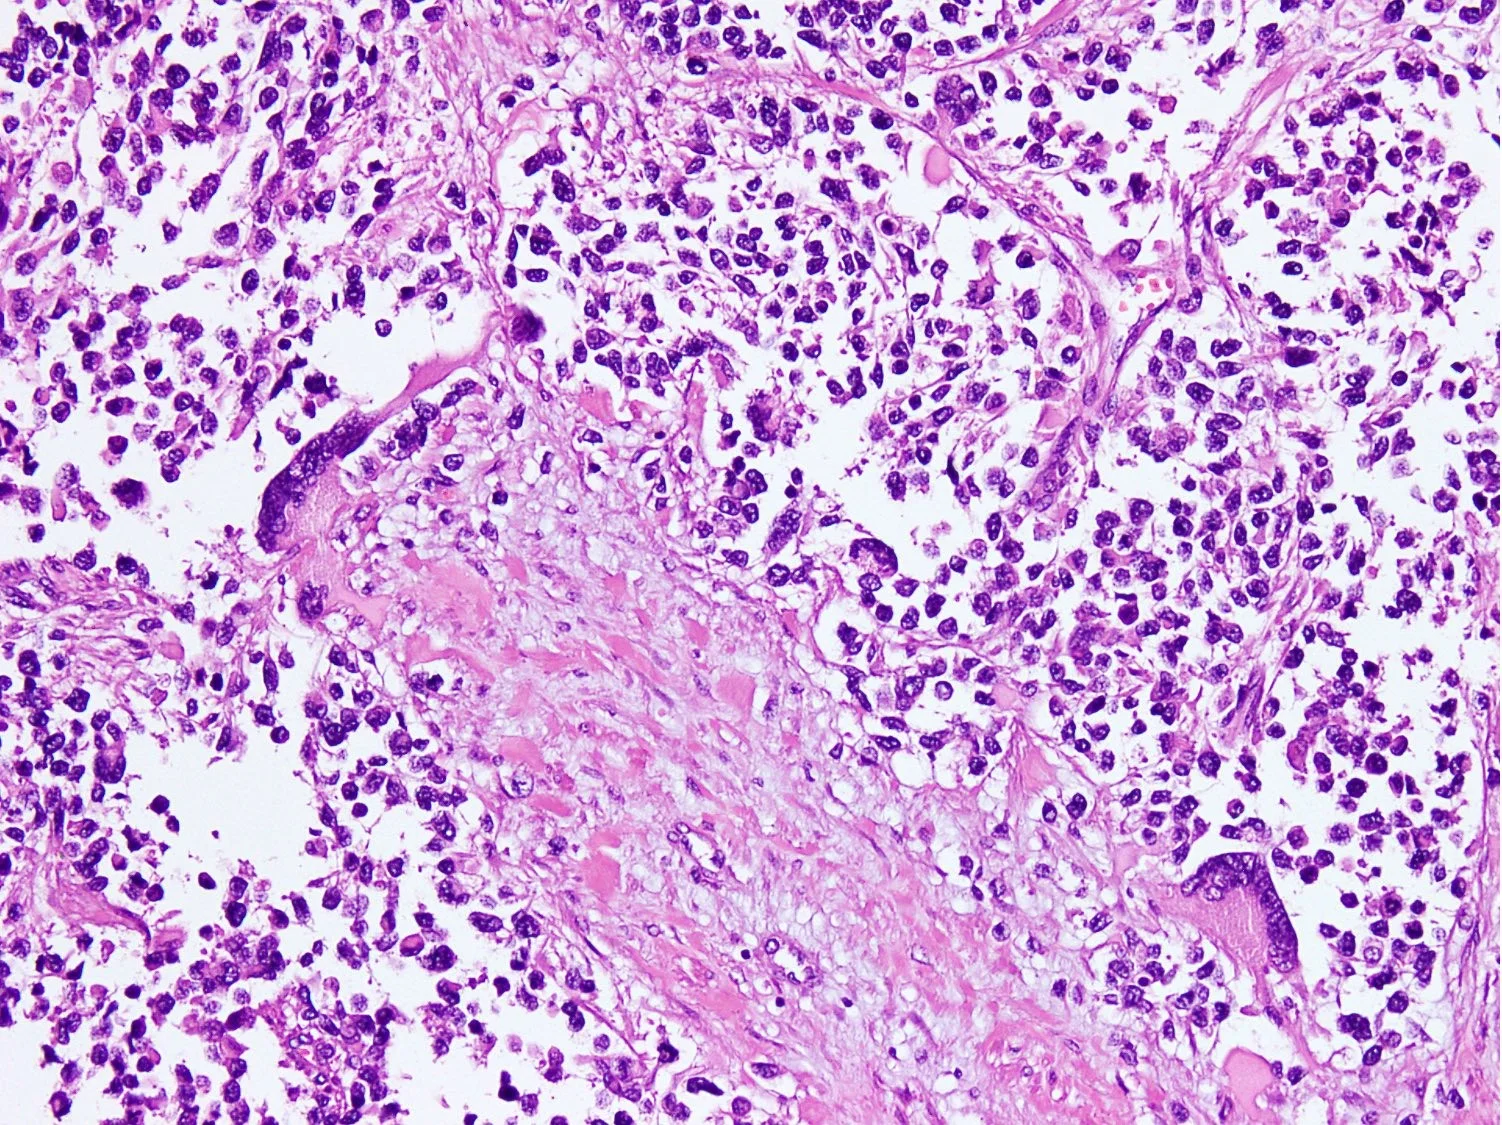
رابدومیوسارکوم آلوئولار
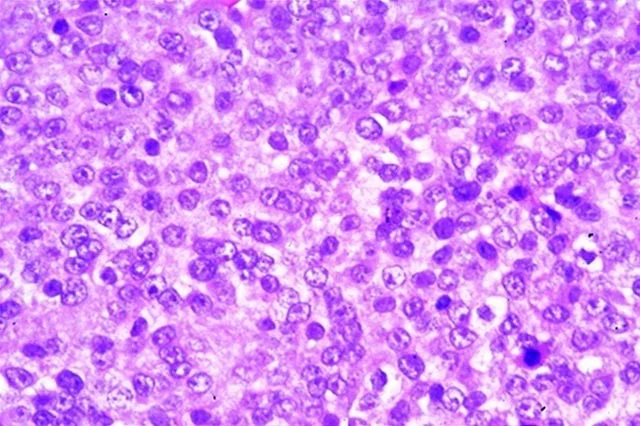
رابدومیوسارکوم آناپلاستیک

رابدومیوسارکوم (Rhabdomyosarcoma) چیست؟
سرطان زمانی شروع میشود که سلولهای بدن شروع به رشد خارج از کنترل میکنند. سلولها تقریباً در هر قسمت از بدن میتوانند به سرطان تبدیل شوند و به سایر نقاط بدن گسترش یابند.
سارکومها (Sarcomas) سرطانهایی هستند که از بافتهای همبند بدن مانند ماهیچهها، چربی، استخوانها، پوشش مفاصل یا رگهای خونی ایجاد میشوند. انواع مختلفی از سارکوم وجود دارد.
رابدومیوسارکوم (RMS) نوعی سارکوم است که از سلولهایی تشکیل شده است که به طور معمول به ماهیچههای اسکلتی (ارادی) تبدیل میشوند. اینها ماهیچههایی هستند که ما آنها را کنترل میکنیم تا قسمتهایی از بدن خود را حرکت دهیم.
خیلی قبل از تولد، سلولهایی به نام رابدومیوبلاست (rhabdomyoblasts، که در نهایت ماهیچههای اسکلتی را تشکیل میدهند) شروع به تشکیل میکنند. اینها سلولهایی هستند که میتوانند به RMS تبدیل شوند. از آن جایی که این سرطان شکلهای اولیه سلولهای عضلانی است، در کودکان بسیار شایع تر است، اگرچه گاهی اوقات در بزرگسالان نیز رخ میدهد.
ما ممکن است فکر کنیم که عضلات اسکلتی خود عمدتاً در بازوها و پاهای ما قرار دارند اما RMS تقریباً در هر جایی از بدن میتواند شروع شود، حتی در برخی از قسمتهای بدن که معمولاً ماهیچههای اسکلتی ندارند.
مکانهای رایج RMS عبارتند از:
- سر و گردن (مانند نزدیک چشم، داخل سینوسهای بینی یا گلو یا نزدیک ستون فقرات در گردن)
- اندامهای ادراری و تناسلی (مثانه، غده پروستات یا هر یک از اندامهای زنانه)
- بازوها و پاها
- تنه (سینه و شکم)
انواع رابدومیوسارکوم
2 نوع اصلی RMS به همراه برخی از انواع کمتر رایج وجود دارد.
رابدومیوسارکوم جنینی (Embryonal rhabdomyosarcoma یا ERMS)
ERMS معمولاً در 5 سال اول زندگی کودکان را تحت تأثیر قرار میدهد اما میتواند در سنین بالاتر نیز رخ دهد.

ERMS تمایل دارد در ناحیه سر و گردن، مثانه، واژن یا در داخل یا اطراف پروستات و بیضهها ایجاد شود.
دو زیرگروه ERMS، رابدومیوسارکومای بوتریوئید (botryoid cell rhabdomyosarcomas) و سلول دوکی (spindle cell rhabdomyosarcomas)، نسبت به شکل مرسوم رایج ERMS، پیش آگهی (چشم انداز) بهتری دارند.
رابدومیوسارکوم آلوئولار (Alveolar rhabdomyosarcoma یا ARMS)
ARMS معمولاً همه گروههای سنی را به طور یکسان تحت تأثیر قرار میدهد. بخش بزرگی از RMS را در کودکان بزرگتر، نوجوانان و بزرگسالان نسبت به کودکان کوچکتر تشکیل میدهد (زیرا ERMS در سنین بالاتر کمتر رایج است).
ARMS اغلب در عضلات بزرگ تنه، بازوها و پاها رخ میدهد.
ARMS سریعتر از ERMS رشد میکند و معمولاً به درمان شدیدتری نیاز دارد. با این حال، در برخی از موارد ARMS، سلولهای سرطانی فاقد تغییرات ژنی خاصی هستند، که باعث میشود این سرطانها بیشتر شبیه ERMS عمل کنند (و به پزشکان اجازه میدهد روند درمان را با شدت کمتری انجام دهند).
رابدومیوسارکوم آناپلاستیک (Anaplastic rhabdomyosarcoma) و سارکوم تمایز نیافته (undifferentiated sarcoma)
رابدومیوسارکوم آناپلاستیک (همچنین رابدومیوسارکوم پلئومورفیک یا pleomorphic rhabdomyosarcoma نیز نامیده میشود) یک نوع ناشایع است که عمدتاً در بزرگسالان رخ میدهد و در کودکان بسیار نادر است.
برخی از پزشکان نیز سارکومهای تمایز نیافته را با رابدومیوسارکوم گروه بندی میکنند. با استفاده از تستهای آزمایشگاهی، پزشکان میتوانند بگویند که این سرطانها سارکوم هستند اما سلولها هیچ ویژگی ندارند که به طبقهبندی بیشتر آنها کمک کند.
هر دوی این سرطانهای غیر معمول به سرعت رشد میکنند و معمولاً به درمان فشرده نیاز دارند.
رابدومیوسارکوم در بزرگسالان
اکثر رابدومیوسارکومها در کودکان و نوجوانان ایجاد میشوند اما میتوانند در بزرگسالان نیز رخ دهند. احتمال بیشتری وجود دارد که بزرگسالان انواع RMS با رشد سریعتر و در قسمتهایی از بدن که درمان آن سختتر است، داشته باشند. به همین دلیل، درمان موثر RMS در بزرگسالان اغلب دشوارتر است.
آمار کلیدی رابدومیوسارکوم
هر ساله حدود 400 تا 500 مورد جدید رابدومیوسارکوم (RMS) در ایالات متحده رخ میدهد. تعداد موارد جدید در طول چند دهه گذشته تغییر چندانی نکرده است.
اکثر رابدومیوسارکومها در کودکان و نوجوانان تشخیص داده میشوند و بیش از نیمی از آنها در کودکان زیر 10 سال تشخیص داده میشوند.
حدود 3 درصد از تمام سرطانهای دوران کودکی RMS هستند. این تومورها معمولاً رابدومیوسارکوم جنینی (ERMS) هستند و تمایل دارند در ناحیه سر و گردن یا در دستگاه تناسلی و ادراری ایجاد شوند. رابدومیوسارکوم آلوئولار (ARMS) همه گروههای سنی را تحت تاثیر قرار میدهد و بیشتر در بازوها، پاها یا تنه (سینه یا شکم) دیده میشود.
RMS در پسران کمی بیشتر از دختران است. به نظر نمیرسد هیچ نژاد یا گروه قومی خاصی دارای نرخ بالای غیر عادی RMS باشد.
پیش آگهی (چشم انداز) برای افراد مبتلا به RMS به عوامل زیادی بستگی دارد، از جمله نوع RMS، محل و اندازه تومور، نتایج جراحی و اینکه آیا سرطان متاستاز داده است (گسترش پیدا کرده است). کودکان 1 تا 9 ساله نسبت به نوزادان یا کودکان بزرگتر یا بزرگسالان دیدگاه بهتری دارند. آمار مربوط به بقا در مبحث میزان بقا برای رابدومیوسارکوم توسط گروه خطری آن مورد بحث قرار گرفته است.
علائم و نشانههای رابدومیوسارکوم
رابدومیوسارکوم (RMS) تقریباً در هر نقطه از بدن میتواند شروع شود، بنابراین علائم RMS میتواند در هر فردی متفاوت باشد. علائم بستگی به این دارد که تومور کجاست، چقدر بزرگ است و آیا به سایر قسمتهای بدن گسترش یافته است.
- هنگامی که تومور در گردن، قفسه سینه، پشت، بازو، پا یا کشاله ران (از جمله بیضهها) باشد، اولین علامت ممکن است وجود یک توده یا تورم باشد که گاهی اوقات میتواند باعث درد، قرمزی یا مشکلات دیگر شود.
- تومورهای اطراف چشم میتوانند باعث برآمدگی چشم یا به نظر رسیدن چشمهای ضربدری شوند. بینایی نیز ممکن است تحت تأثیر قرار گیرد.
- تومورهای گوش یا سینوسهای بینی میتوانند باعث گوش درد، سردرد، خونریزی بینی یا احتقان سینوسی شوند.
- تومور در مثانه یا پروستات میتواند منجر به خون در ادرار شود، در حالی که تومور در واژن میتواند باعث خونریزی واژینال شود. این تومورها ممکن است به اندازه ای بزرگ شوند که ادرار کردن یا حرکات روده را سخت یا دردناک کنند.
- تومورهای شکم یا لگن میتوانند باعث استفراغ، درد شکم یا یبوست شوند.
- RMS به ندرت در مجاری صفراوی (لولههای کوچکی که از کبد به رودهها منتهی میشوند) ایجاد میشود اما زمانی که ایجاد میشود میتواند باعث زردی چشم یا پوست (یرقان) شود.
- اگر RMS پیشرفته تر شود، میتواند علائمی مانند تودههای زیر پوست (اغلب در گردن، زیر بازو یا کشاله ران)، درد استخوان، سرفه مداوم، ضعف یا کاهش وزن ایجاد کند.
یک یا چند مورد از این علائم معمولا منجر به مراجعه به پزشک میشود. بسیاری از این علائم و نشانهها به احتمال زیاد توسط چیزی غیر از RMS ایجاد میشوند. به عنوان مثال، کودکان و نوجوانان ممکن است برآمدگی یا درد ناشی از بازی یا آسیبهای ورزشی داشته باشند. با این حال، اگر شما یا فرزندتان هر یک از این علائم را دارید که در عرض یک هفته یا بیشتر از بین نمیروند (یا اگر بدتر میشوند)، به پزشک مراجعه کنید تا در صورت نیاز بتوان علت را پیدا کرده و آن را درمان کرد.
چه چیزی باعث رابدومیوسارکوم میشود؟
علت بیشتر موارد رابدومیوسارکوم (RMS) به خوبی شناخته نشده است و عوامل خطرزا بسیار کمی برای این نوع سرطان شناخته شده است اما محققان در حال فهم این موضوع هستند که چگونه سلولهای طبیعی به دلیل تغییرات خاصی در DNA آنها سرطانی میشوند.
DNA ماده شیمیایی موجود در هر یک از سلولهای ما است که ژنهای ما را میسازد و عملکرد سلولهای ما را کنترل میکند. ژنها در کروموزومها (رشتههای بلند DNA در هر سلول) بسته بندی میشوند. ما معمولاً در هر سلول 23 جفت کروموزوم داریم (یک مجموعه کروموزوم از هر والدین میآید). ما معمولا شبیه والدین خود هستیم زیرا آنها منبع DNA ما هستند. اما DNA بر چیزی بیشتر از ظاهر ما تأثیر میگذارد.
برخی از ژنها زمان رشد سلولهای ما، تقسیم به سلولهای جدید و مرگ را کنترل میکنند:
- ژنهایی که به رشد، تقسیم یا زنده ماندن سلولها کمک میکنند، انکوژن (oncogenes) نامیده میشوند.
- ژنهایی که تقسیم سلولی را کند میکنند یا سلولها را در زمان مناسب میمیرند، ژنهای سرکوب کننده تومور (tumor suppressor genes) نامیده میشوند.
سرطانها میتوانند ناشی از تغییرات DNA باشند که انکوژنها را فعال میکند یا ژنهای سرکوب کننده تومور را خاموش میکند.
تغییرات ژنی موثر بر RMS
بخش کوچکی از افراد مبتلا به RMS تغییرات ژنی را از والدین به ارث برده اند که آنها را در معرض خطر بیشتری قرار میدهد. به عنوان مثال، افراد مبتلا به سندرم Li-Fraumeni تغییراتی در ژن سرکوبگر تومور TP53 دارند که باعث میشود پروتئین p53 معیوب بسازد. پروتئین p53 به طور معمول باعث میشود سلولهای آسیب دیده به DNA آن آسیب را متوقف کرده و ترمیم کنند یا در صورت عدم امکان ترمیم، خودشان را تخریب کنند. هنگامی که p53 کار نمیکند، سلولهای دارای آسیب DNA به تقسیم شدن ادامه میدهند که میتواند منجر به نقص بیشتر در ژنهای دیگر و در نهایت سرطان شود.
تغییرات ژن در ARMS
زمانی که تکههای DNA از یک کروموزوم به کروموزوم دیگر تغییر میکنند، میتوان ژنهای خاصی را در یک سلول روشن کرد. این نوع تغییر که جابهجایی (translocation) نامیده میشود، زمانی رخ میدهد که یک سلول در حال تقسیم شدن به 2 سلول جدید است. به نظر میرسد که این علت بیشتر موارد رابدومیوسارکوم آلوئولار (ARMS) باشد.
در این سرطانها، یک قطعه کوچک از کروموزوم 2 (یا در موارد کمتر کروموزوم 1) اغلب به کروموزوم 13 ختم میشود. این ژنی به نام PAX3 (یا PAX7 اگر کروموزوم 1 باشد) را دقیقاً در کنار ژنی به نام FOXO1 حرکت میدهد و یک ژن همجوشی PAX/FOX01 ایجاد میکند.
ژنهای PAX نقش مهمی در رشد سلولی دارند در حالی که بافت ماهیچهای جنین در حال شکل گیری است اما این ژنها معمولاً زمانی که دیگر مورد نیاز نیستند، خاموش میشوند. حرکت یکی از آنها در کنار ژن FOXO1 باعث فعال نگه داشتن ژن PAX میشود که به نظر میرسد همان چیزی است که منجر به تشکیل تومور میشود.

جابجاییهای دیگر یا انواع دیگر تغییرات ژنی نیز گاهی در ARMS دیده میشود. در واقع، حدود 1 مورد از هر 4 مورد سرطانی که پزشکان معمولاً آنها را به عنوان ARMS طبقه بندی میکنند، مشخص شده است که ژن همجوشی PAX/FOXO1 که معمولاً در ARMS دیده نمیشود را ندارند. پزشکان دریافته اند که این سرطانها بیشتر شبیه رابدومیوسارکوم جنینی (ERMS) عمل میکنند که معمولاً به درمان فشردهتری نسبت به ARMS نیاز دارد.
تغییرات ژن در ERMS
تحقیقات نشان میدهد که رابدومیوسارکوم جنینی (ERMS) به روشی متفاوت رشد میکند. سلولهای این تومور به طور معمول یک قطعه کوچک از کروموزوم 11 را که از مادر یک فرد گرفته شده است، از دست داده اند و با نسخه دوم آن قسمت از کروموزوم از پدرشان جایگزین شده است. به نظر میرسد این باعث میشود که ژن IGF2 روی کروموزوم 11 بیش فعال شود. ژن IGF2 پروتئینی را کد میکند که میتواند این سلولهای تومور را رشد دهد. سایر تغییرات ژنی احتمالاً در این تومورها نیز مهم است.
سایر تغییرات ژنی
برای تبدیل شدن سلولهای طبیعی به سلولهای سرطانی معمولاً تغییرات در چندین ژن مختلف لازم است. دانشمندان برخی تغییرات ژنی دیگر را یافته اند که برخی از سلولهای RMS را از سلولهای طبیعی متمایز میکند اما احتمالاً موارد دیگری نیز وجود دارند که هنوز پیدا نشده اند.
چه چیزی باعث تغییرات ژن میشود؟
اکنون محققان بسیاری از تغییرات ژنی را که میتواند منجر به RMS شود، درک کرده اند اما هنوز مشخص نیست که چه چیزی باعث این تغییرات میشود. برخی از تغییرات ژنی را میتوان از والدین به ارث برد. برخی دیگر ممکن است فقط یک رویداد تصادفی باشد که گاهی اوقات در داخل یک سلول اتفاق میافتد، بدون اینکه علت خارجی داشته باشد. هیچ دلیل شناخته شده ای برای RMS مرتبط با سبک زندگی یا محیطی وجود ندارد، بنابراین مهم است بدانید که کودکان مبتلا به RMS یا والدین آنها کاری نمیتوانند برای پیشگیری از این سرطانها انجام دهند.
عوامل خطرزا برای رابدومیوسارکوم
عامل خطرزا هر چیزی است که بر شانس ابتلا به بیماری مانند سرطان تأثیر میگذارد. سرطانهای مختلف عوامل خطرزا متفاوتی دارند.
عوامل خطرزا مرتبط با سبک زندگی مانند وزن بدن، فعالیت بدنی، رژیم غذایی و مصرف دخانیات نقش عمده ای در بسیاری از سرطانهای بزرگسالان دارند اما این عوامل معمولاً سالها طول میکشد تا بر خطر سرطان تأثیر بگذارند و تصور نمیشود که نقش زیادی در سرطانهایی که در دوران کودکی شایع تر هستند، از جمله رابدومیوسارکوم (RMS) ایفا کنند.
سن و جنس
RMS در کودکان کمتر از 10 سال شایع تر است اما میتواند در نوجوانان و بزرگسالان نیز ایجاد شود. این بیماری در پسران کمی بیشتر از دختران است.
شرایط ارثی
برخی از افراد تمایل به ابتلا به انواع خاصی از سرطان دارند زیرا تغییراتی را در DNA (ژن) خود از والدین خود به ارث برده اند. برخی از شرایط ارثی نادر خطر ابتلا به RMS (و معمولاً برخی دیگر از تومورها) را نیز افزایش میدهند:
- اعضای خانوادههای مبتلا به سندرم Li-Fraumeni بیشتر در معرض ابتلا به سارکوم (از جمله RMS)، سرطان سینه، لوسمی و برخی سرطانهای دیگر هستند.
- کودکان مبتلا به سندرم Beckwith-Wiedemann در معرض خطر بالایی برای ابتلا به تومور Wilms – نوعی سرطان کلیه – هستند اما احتمال ابتلای آنها به RMS و برخی دیگر از انواع سرطان دوران کودکی نیز بیشتر است.
- نوروفیبروماتوز (Neurofibromatosis) نوع 1 که به عنوان بیماری فون رکلینهاوزن (Recklinghausen disease) نیز شناخته میشود، معمولاً باعث ایجاد تومورهای عصبی متعدد (به ویژه در اعصاب پوست) میشود اما خطر ابتلا به RMS را نیز افزایش میدهد.
- سندرم کاستلو (Costello syndrome) بسیار نادر است. کودکان مبتلا به این سندروم وزن هنگام تولد بالایی دارند اما پس از آن به خوبی رشد نمیکنند و کوتاه قد هستند. آنها همچنین تمایل به داشتن سر بزرگ دارند. آنها مستعد ابتلا به RMS و همچنین برخی تومورهای دیگر هستند.
- سندرم نونان (Noonan syndrome) وضعیتی است که در آن کودکان تمایل به کوتاه قد بودن داشته، نقص قلبی دارند و میتواند در رشد مهارتهای فیزیکی و یادگیری چیزها کندتر از کودکان معمولی باشد. آنها همچنین در معرض خطر بیشتری برای RMS هستند.
این شرایط نادر هستند و تنها بخش کوچکی از موارد RMS را تشکیل میدهند اما آنها پیشنهاد میکنند که کلید درک RMS ممکن است از مطالعه ژنها و نحوه عملکرد آنها در مراحل اولیه زندگی برای کنترل رشد و توسعه سلولی باشد.
قرار گرفتن در معرض عوامل خطرزا قبل از تولد
برخی از مطالعات نشان داده اند که قرار گرفتن در معرض اشعه ایکس قبل از تولد ممکن است با افزایش خطر RMS در کودکان خردسال مرتبط باشد. استفاده والدین از مواد مخدر مانند ماری جوانا و کوکائین نیز به عنوان یک عامل خطرزا احتمالی مطرح شده است اما مطالعاتی که این پیوندها را پیدا کرده اند، اندک بوده اند و تحقیقات بیشتری لازم است تا ببینیم آیا این عوامل واقعاً با RMS مرتبط هستند یا خیر.
آیا رابدومیوسارکوم قابل پیشگیری است؟
خطر ابتلا به بسیاری از سرطانها که معمولاً در بزرگسالان رخ میدهد را میتوان با تغییرات خاصی در سبک زندگی کاهش داد (مانند حفظ وزن سالم یا ترک سیگار) اما در حال حاضر هیچ راه شناخته شدهای برای پیشگیری از بیشتر سرطانها در کودکان وجود ندارد.
تنها عوامل خطرزا شناخته شده برای رابدومیوسارکوم (RMS) – سن، جنس و برخی شرایط ارثی – قابل تغییر نیستند. هیچ دلیل ثابت شده ای برای RMS مرتبط با سبک زندگی یا محیطی وجود ندارد، بنابراین در حال حاضر هیچ راه شناخته شده ای برای محافظت در برابر این سرطانها وجود ندارد.
آیا رابدومیوسارکوما زود تشخیص داده میشود؟
رابدومیوسارکوم (RMS) شایع نیست و در حال حاضر هیچ آزمایش غربالگری توصیه شده ای برای این سرطانها وجود ندارد. (غربالگری آزمایش بررسی وجود بیماری مانند سرطان در افرادی است که هیچ علامتی ندارند.)
با این حال، RMS اغلب علائمی را ایجاد میکند که اجازه میدهد قبل از گسترش به سایر قسمتهای بدن پیدا شود. بسیاری از علائمی که ممکن است به RMS اشاره کنند میتوانند دلایل دیگری نیز داشته باشند و بیشتر آنها جدی نیستند اما مهم است که آنها را توسط پزشک بررسی کنید. این شامل هر درد، تورم یا تودههایی است که به سرعت رشد میکنند یا بعد از یک هفته از بین نمیروند.
حدود 4 مورد از 5 مورد این سرطانها قبل از اینکه سرطان به وضوح به قسمت دیگری از بدن گسترش یابد، یافت میشود اما حتی زمانی که این اتفاق میافتد، تومورهای بسیار کوچک (که با آزمایشهای تصویر برداری قابل مشاهده، احساس یا تشخیص نیستند) میتوانند به سایر قسمتهای بدن گسترش یافته باشند. به همین دلیل است که هم جراحی و هم سایر درمانها معمولاً برای RMS مورد نیاز است.
برای افرادی که شرایط ارثی خاصی مرتبط با RMS دارند
خانوادههایی که ناقل بیماریهای ارثی هستند که خطر RMS را افزایش میدهد (موجود در فهرست عوامل خطرزا برای رابدومیوسارکوم) یا دارای چندین عضو خانواده مبتلا به سرطان (به ویژه سرطانهای دوران کودکی) هستند، باید با پزشک خود در مورد نیاز احتمالی به معاینات مکرر صحبت کنند.
بروز RMS در خانوادهها معمول نیست اما توجه دقیق به علائم اولیه احتمالی سرطان ممکن است به یافتن زود هنگام آن کمک کند، زمانی که درمان به احتمال زیاد موفقیت آمیز باشد.
آزمایشات رابدومیوسارکوم
برخی از علائم و نشانهها ممکن است نشان دهند که فرد مبتلا به رابدومیوسارکوم (RMS) است اما آزمایشهایی برای اطمینان یافتن از آن لازم است.
سابقه پزشکی و معاینه فیزیکی
اگر شما یا فرزندتان علائمی دارید که میتواند ناشی از RMS (یا نوع دیگری از تومور) باشد، پزشک میخواهد یک تاریخچه پزشکی کامل بگیرد تا درباره علائم شما بیشتر بداند.
پزشک همچنین یک معاینه فیزیکی برای بررسی علائم احتمالی RMS یا سایر مشکلات سلامتی انجام میدهد. برای مثال، پزشک ممکن است بتواند یک توده یا تورم غیر طبیعی را ببیند یا احساس کند.
اگر پزشک به RMS (یا نوع دیگری از تومور) مشکوک باشد، آزمایشاتی برای پیدا کردن آن لازم است. اینها ممکن است شامل آزمایشهای تصویر برداری، بیوپسی و یا تستهای آزمایشگاهی باشد.
تستهای تصویر برداری
تستهای تصویر برداری از اشعه ایکس، میدانهای مغناطیسی، مواد رادیواکتیو یا امواج صوتی برای ایجاد تصاویری از داخل بدن استفاده میکنند. آزمایشهای تصویر برداری ممکن است به دلایلی انجام شود، از جمله:
- برای کمک به یافتن اینکه آیا یک ناحیه مشکوک ممکن است سرطان باشد یا خیر.
- برای تعیین وسعت تومور یا یادگیری میزان گسترش سرطان
- برای کمک به تعیین اینکه آیا روند درمان موثر است یا خیر.
افرادی که RMS دارند یا ممکن است داشته باشند، یک یا چند مورد از این تستها را انجام خواهند داد.
اشعه ایکس ساده
گاهی اوقات از اشعه ایکس برای جستجوی تومورها استفاده میشود اما برای بررسی استخوانها بهترین روش است. آنها جزئیات زیادی را در اندامهای داخلی نشان نمیدهند، بنابراین سایر آزمایشات تصویر برداری معمولاً هنگام جستجوی تومورهای بافت نرم مانند RMS مفیدتر هستند.
رادیوگرافی قفسه سینه گاهی اوقات برای بررسی سرطانی که ممکن است به ریهها سرایت کرده باشد انجام میشود، اگرچه در صورت انجام سی تی اسکن قفسه سینه، نیازی به آن نیست.
اسکن توموگرافی کامپیوتری (CT یا Computed tomography)

سی تی اسکن بسیاری از تصاویر اشعه ایکس را ترکیب میکند تا تصاویر مقطعی دقیقی از قسمتهایی از بدن، از جمله بافتهای نرم مانند ماهیچهها ایجاد کند. ماده حاجب ممکن است قبل از اسکن به داخل ورید تزریق شود تا به دیدن جزئیات بهتر کمک کند.
این آزمایش اغلب میتواند تومور را با جزئیات نشان دهد، از جمله اینکه چقدر بزرگ است و آیا به ساختارهای مجاور رشد کرده است. همچنین میتوان از آن برای مشاهده غدد لنفاوی مجاور و همچنین ریهها یا سایر نواحی بدن که ممکن است سرطان در آن جا گسترش یافته باشد، استفاده کرد.
اسکن تصویر برداری رزونانس مغناطیسی (MRI یا Magnetic resonance imaging)

اسکن MRI تصاویر دقیقی را با استفاده از امواج رادیویی و آهنرباهای قوی به جای اشعه ایکس ایجاد میکند، بنابراین هیچ تشعشعی در کار نیست. ماده حاجب به نام گادولینیوم (gadolinium) ممکن است قبل از اسکن به داخل ورید تزریق شود تا به دیدن جزئیات بهتر کمک کند.
این آزمایش ممکن است به جای سی تی اسکن برای مشاهده تومور و بافتهای اطراف آن استفاده شود. MRI مخصوصاً در صورتی مفید است که تومور در قسمتهای خاصی از بدن مانند سر و گردن، بازو یا پا یا لگن باشد. اسکن MRI میتواند به تعیین وسعت دقیق تومور کمک کند زیرا میتواند عضله، چربی و بافت همبند اطراف تومور را با جزئیات زیاد نشان دهد. این هنگام برنامه ریزی برای جراحی یا پرتو درمانی مهم است. MRI همچنین در صورتی که پزشک نگران انتشار احتمالی آن به نخاع یا مغز باشد بسیار مفید است.
اسکن استخوان
اسکن استخوان میتواند نشان دهد که آیا سرطان به استخوانها سرایت کرده است یا خیر. این آزمایش به این دلیل مفید است که تصویری از کل اسکلت را در یک زمان ارائه میدهد.
برای این آزمایش، مقدار کمی از مواد رادیواکتیو سطح پایین به خون تزریق میشود و به استخوانها میرود. یک دوربین مخصوص میتواند رادیواکتیویته را تشخیص دهد و تصویری از اسکلت ایجاد کند.
نواحی تغییرات استخوانی فعال، رادیواکتیویته را جذب کرده و به صورت “نقاط داغ یا hot spots” در اسکن نشان داده میشود. این نواحی ممکن است نشان دهنده سرطان در یک ناحیه باشند اما سایر بیماریهای استخوانی نیز میتوانند همین الگو را ایجاد کنند، بنابراین آزمایشهای دیگری مانند عکس برداری با اشعه ایکس ساده یا اسکن MRI یا حتی بیوپسی استخوان ممکن است مورد نیاز باشد.
(در صورت انجام اسکن توموگرافی گسیل پوزیترون [PET] ممکن است نیازی به اسکن استخوان نباشد زیرا اسکن PET اغلب میتواند اطلاعات مشابهی را ارائه دهد.)
اسکن توموگرافی گسیل پوزیترون (PET یا Positron emission tomography)
برای اسکن PET، یک ماده رادیواکتیو (معمولا نوعی قند مربوط به گلوکز، معروف به FDG) به خون تزریق میشود. از آن جایی که سلولهای سرطانی به سرعت رشد میکنند، مقادیر زیادی از قند را جذب میکنند. سپس یک دوربین مخصوص میتواند تصویری از مناطق پرتوزا در بدن ایجاد کند. تصویر مانند سی تی اسکن یا ام آر آی دقیق نیست اما اطلاعات مفیدی در مورد کل بدن ارائه میدهد.
اسکن PET گاهی اوقات میتواند برای یافتن اینکه آیا نواحی مشکوکی که در سایر آزمایشات تصویر برداری مشاهده میشود (مانند اسکن استخوان یا سی تی اسکن) تومور هستند، مفید باشد. اسکن PET همچنین میتواند در طول روند درمان تکرار شود تا میزان عملکرد آن مشخص شود.
برخی از دستگاهها میتوانند همزمان PET و CT اسکن (PET/CT scan) انجام دهند. این به پزشک اجازه میدهد مناطق با رادیواکتیویته بالاتر در اسکن PET را با ظاهر دقیقتر آن ناحیه در سی تی اسکن مقایسه کند.
سونوگرافی (Ultrasound)
اولتراسوند از امواج صوتی و پژواک آنها برای ایجاد تصویری از اندامهای داخلی یا تومورها استفاده میکند. برای این آزمایش، یک ابزار کوچک گرز مانند به نام مبدل روی پوست حرکت داده میشود (که ابتدا با ژل روغن کاری میشود). این مبدل امواج صوتی را منتشر میکند و پژواکها را هنگام جهش از اندامها دریافت میکند. پژواکها توسط کامپیوتر به تصویر روی صفحه تبدیل میشوند.
از سونوگرافی میتوان برای مشاهده اینکه آیا تومورهای لگن (مانند تومورهای پروستات یا مثانه) در طول زمان در حال رشد یا کوچک شدن هستند، استفاده کرد. (این آزمایش را نمیتوان برای بررسی تومورهای قفسه سینه استفاده کرد زیرا دندهها امواج صوتی را مسدود میکنند.) انجام این آزمایش آسان است و از تشعشع استفاده نمیکند.
بیوپسی (Biopsy)
نتایج یک معاینه فیزیکی یا آزمایشهای تصویر برداری ممکن است نشان دهد که فردی مبتلا به RMS (یا نوع دیگری از تومور بافت نرم) است اما بیوپسی (حذف بخشی از تومور برای مشاهده زیر میکروسکوپ و سایر تستهای آزمایشگاهی) تنها راه مسلم یا قطعی است.
بیوپسی را میتوان به روشهای مختلفی انجام داد. رویکرد مورد استفاده بستگی به محل تومور، سن بیمار و تخصص و تجربه پزشک انجام دهنده بیوپسی دارد.
بیوپسی جراحی (Surgical biopsy)
رایج ترین روش بیوپسی برداشتن یک قطعه کوچک از تومور در حین جراحی است در حالی که بیمار تحت بیهوشی عمومی (خواب) قرار دارد. در برخی موارد، غدد لنفاوی مجاور نیز برداشته میشوند تا ببینند آیا تومور به آنها سرایت کرده است یا خیر. سپس نمونهها به آزمایشگاه فرستاده شده و مورد آزمایش قرار میگیرند.
بیوپسیهای سوزنی (Needle biopsies)
اگر به دلایلی نتوان بیوپسی جراحی انجام داد، بیوپسی کمتر تهاجمی با استفاده از یک سوزن نازک و توخالی ممکن است انجام شود. 2 نوع بیوپسی سوزنی وجود دارد که هر کدام مزایا و معایبی دارند.
بیوپسی با سوزن مرکزی (Core needle biopsy): برای بیوپسی با سوزن مرکزی، پزشک یک سوزن توخالی را وارد تومور میکند تا تکهای از آن را خارج کند (که به عنوان نمونه هسته ای یا مرکزی شناخته میشود). اگر تومور درست زیر پوست باشد، پزشک میتواند با لمس کردن سوزن را به داخل تومور هدایت کند اما اگر تومور در اعماق بدن باشد، ممکن است برای کمک به هدایت سوزن در جای خود، آزمایشهای تصویر برداری مانند سونوگرافی یا سی تی اسکن مورد نیاز باشد. سپس نمونه برداشته شده برای آزمایش به آزمایشگاه فرستاده میشود.

مزیت اصلی بیوپسی با سوزن مرکزی این است که نیازی به جراحی ندارد، بنابراین برش بزرگی وجود ندارد. بسته به محل تومور، بزرگسالان و کودکان بزرگتر ممکن است نیازی به بیهوشی عمومی نداشته باشند (حالتی که برای انجام بیوپسی در خواب هستند) اما برخی از کودکان کوچکتر ممکن است نیاز داشته باشند که بیهوش شوند. از طرف دیگر، نمونه کوچکتر از نمونه برداری جراحی است و اگر سوزن به درستی نشانه نرود، ممکن است تومور را از دست بدهد. اگر نمونه، نمونه خوبی از تومور نباشد، بیوپسی دیگری مورد نیاز است.
بیوپسی آسپیراسیون با سوزن ظریف (FNA یا Fine needle aspiration): برای این روش، پزشک از یک سوزن بسیار نازک و توخالی متصل به سرنگ استفاده میکند تا نمونه کوچک تومور را بیرون بکشد. بیوپسی FNA برای تومورهایی که به راحتی قابل دسترسی هستند (مانند آنهایی که درست زیر پوست هستند) مناسب است، اگرچه میتوان از آن برای تومورهای عمیق تر در بدن نیز استفاده کرد.
نقطه ضعف FNA این است که نمونه بسیار کوچک است. پاتولوژیست باید با این تکنیک تجربه داشته باشد و بتواند تصمیم بگیرد که کدام تستهای آزمایشگاهی در یک نمونه بسیار کوچک مفیدتر است. در مراکز سرطانی که تجربه استخراج بیشترین اطلاعات از مقادیر بسیار کمی از بافت را دارند، FNA میتواند روشی ارزشمند – البته مطمئناً بیخطر – برای تشخیص RMS باشد اما معمولاً روش بیوپسی ترجیحی نیست.

آسپیراسیون مغز استخوان (Bone marrow aspiration) و بیوپسی

این آزمایشات اغلب پس از تشخیص RMS انجام میشود تا مشخص شود آیا سرطان به مغز استخوان (بخشهای داخلی نرم برخی از استخوانها) گسترش یافته است یا خیر.
2 آزمایش معمولاً همزمان انجام میشود. نمونهها معمولاً از پشت هر دو استخوان لگن (hip) گرفته میشوند اما در برخی بیماران ممکن است از استخوانهای دیگر برداشته شوند.
این آزمایشات ممکن است در حین عمل جراحی برای بیوپسی یا برداشتن تومور اصلی (در حالی که کودک هنوز تحت بیهوشی است) انجام شود یا ممکن است به عنوان یک روش جداگانه انجام شود.
اگر آسپیراسیون مغز استخوان به صورت جداگانه انجام شود، بیمار روی میز (به پهلو یا شکم) دراز میکشد. پس از تمیز کردن پوست لگن، پزشک ناحیه و سطح استخوان را با بیحس کننده موضعی بی حس میکند که میتواند برای مدت کوتاهی دچار گزش یا سوختگی شود. همچنین ممکن است به کودکان داروهای دیگری داده شود تا به آنها کمک کند تا آرام شوند یا حتی برای این عمل بخوابند. سپس یک سوزن نازک و توخالی به استخوان وارد میشود و از یک سرنگ برای مکیدن مقدار کمی از مغز استخوان مایع استفاده میشود.
بیوپسی مغز استخوان معمولاً درست بعد از آسپیراسیون انجام میشود. تکههای کوچک استخوان و مغز را با یک سوزن کمی بزرگتر که به پایین به داخل استخوان فشار میدهند، برداشته میشوند. پس از انجام بیوپسی، فشار به محل برای کمک به توقف هرگونه خونریزی وارد میشود.
نمونههای استخوان و مغز به آزمایشگاه فرستاده میشوند و در آن جا بررسی شده و برای سلولهای سرطانی آزمایش میشوند.
پونکسیون کمری (spinal tap یا Lumbar puncture)

این یک آزمایش رایج برای RMS نیست اما ممکن است برای تومورهای سر در نزدیکی پوشش مغز (مننژها یا meninges) انجام شود. این آزمایش برای جستجوی سلولهای سرطانی در مایع مغزی نخاعی (cerebrospinal fluid یا CSF) که مایعی است که مغز و نخاع را احاطه میکند، استفاده میشود.
برای این آزمایش، پزشک ابتدا ناحیهای در قسمت پایین کمر نزدیک به ستون فقرات را بیحس میکند. همچنین پزشک ممکن است توصیه کند که به کودک چیزی داده شود تا او را بخواباند تا ضربه زدن به ستون فقرات بدون مشکل یا ایجاد آسیب انجام شود. سپس یک سوزن کوچک و توخالی بین استخوانهای ستون فقرات وارد میشود تا مقداری از مایع خارج شود و سپس برای آزمایش به آزمایشگاه فرستاده میشود.
تستهای آزمایشگاهی بر روی نمونههای بیوپسی
دکتری به نام پاتولوژیست نمونههای بیوپسی را زیر میکروسکوپ بررسی میکند تا ببیند آیا سلولهای سرطانی در آنها وجود دارد یا خیر. اگر سرطان پیدا شد، قدم بعدی این است که بفهمید آیا سرطان RMS است یا خیر. در موارد نادر، پاتولوژیست میتواند ببیند که سلولهای سرطانی دارای خطوط عضلانی کوچکی هستند که به تایید RMS بودن سرطان کمک میکند اما اغلب برای اطمینان از تستهای آزمایشگاهی دیگری نیاز است.
آسیب شناس ممکن است از رنگهای خاصی روی نمونهها برای شناسایی نوع تومور استفاده کند. این رنگها حاوی پروتئینهای خاصی (آنتی بادی) هستند که به مواد موجود در سلولهای RMS متصل میشوند اما به سایر سرطانها نمیچسبند. رنگها ماده مشخصی را تولید میکنند که زیر میکروسکوپ قابل مشاهده است. این به پاتولوژیست اجازه میدهد تا بداند که تومور یک رابدومیوسارکوم است.
اگر تشخیص RMS داده شود، پاتولوژیست همچنین از تستهای آزمایشگاهی ویژه برای کمک به تعیین نوع RMS استفاده میکند. این امر مهم است زیرا بر نحوه درمان سرطان تأثیر میگذارد. برای مثال، رابدومیوسارکوم آلوئولار (ARMS) که تمایل به تهاجمیتر بودن دارد، معمولاً به درمان شدیدتری نسبت به رابدومیوسارکوم جنینی (ERMS) نیاز دارد. بخش مهمی از این آزمایش، جستجوی تغییرات ژنی یا کروموزومی در سلولهای سرطانی است، مانند مواردی که در مبحث چه عواملی باعث رابدومیوسارکوم میشود؟ گفته شد.
آزمایشات خون
برای تشخیص RMS نمیتوان از آزمایش خون استفاده کرد اما برخی از آزمایشات خون ممکن است پس از تشخیص مفید باشد.
شمارش کامل خون (complete blood count یا CBC) سطح گلبولهای سفید، گلبولهای قرمز و پلاکتها را در خون اندازه گیری میکند. اگر نتیجه CBC در زمان تشخیص غیر طبیعی باشد، میتواند به این معنی باشد که سرطان به مغز استخوان – جایی که این سلولهای خونی ساخته میشوند – گسترش یافته است. این آزمایش همچنین میتواند در طول روند درمان (مانند شیمی درمانی) برای بررسی مشکلات احتمالی یا عوارض جانبی استفاده شود.
آزمایشات شیمی خون میتواند برای اندازه گیری میزان عملکرد کبد و کلیهها و همچنین میزان برخی مواد معدنی در خون مورد استفاده قرار گیرد.
مراحل رابدومیوسارکوم و گروههای خطر
هنگامی که رابدومیوسارکوم (RMS) تشخیص داده و نوع RMS شناسایی شد، پزشکان باید میزان سرطان و محل گسترش آن را ارزیابی کنند. این کار به عنوان مرحله سرطان (stage of the cancer) شناخته میشود. مرحله یکی از مهم ترین عوامل در تعیین پیش آگهی (چشم انداز) یک فرد است. همچنین هنگام تصمیم گیری در مورد بهترین گزینههای درمانی، مهم است.
پزشکان از نتایج آزمایشهای تصویر برداری و بیوپسی و معاینه اندامها در حین جراحی استفاده میکنند تا بفهمند سرطان چقدر گسترش یافته است. اگر شکی در مورد وسعت سرطان وجود داشته باشد، بیوپسیهای بیشتری یا آزمایشهای دیگر ممکن است انجام شود.
مرحله RMS متفاوت از اکثر سرطانهای دیگر است. پزشکان ابتدا 3 اطلاعات کلیدی را تعیین میکنند:
- مرحله TNM
- گروه بالینی
- آیا سلولهای سرطانی دارای ژن همجوشی PAX/FOX01 هستند یا خیر.
از این عوامل برای تقسیم بیماران به گروههای خطر استفاده میشود که سپس برای هدایت روند درمان مورد استفاده قرار میگیرد.
مراحل و گروههای خطر برای RMS میتواند گیج کننده باشد. اگر سؤالی در مورد مرحله بندی یا گروههای خطر دارید، از پزشک یا پرستار بخواهید که آن را به گونه ای که شما درک میکنید برایتان توضیح دهد.
مرحله TNM
مرحله TNM قبل از شروع رون درمان تعیین میشود و بر اساس 3 اطلاعات کلیدی است:
- T: مشخصات تومور اصلی (محل و اندازه)
- N: آیا سرطان به غدد لنفاوی مجاور سرایت کرده است (مجموعه سلولهای سیستم ایمنی به اندازه یک لوبیا)
- M: اینکه آیا سرطان به نقاط دور دست بدن متاستاز داده است یا خیر.
این عوامل برای تعیین یک مرحله کلی با یکدیگر ترکیب میشوند:
مرحله 1
تومور در ناحیه مطلوب شروع شده است:
- مدار (ناحیه اطراف چشم)
- ناحیه سر و گردن، به جز نواحی پارامننژیال (parameningeal، نواحی موجود در کنار غشای پوشاننده مغز، مانند مجرای بینی و سینوسهای مجاور، گوش میانی و بالاترین قسمت گلو)
- یک ناحیه تناسلی یا ادراری، به جز مثانه یا غده پروستات
- مجاری صفراوی (لولههایی که از کبد به رودهها منتهی میشوند)
تومور میتواند هر اندازه ای داشته باشد. ممکن است در نواحی مجاور رشد کرده باشد و یا به غدد لنفاوی مجاور گسترش یافته باشد اما به نقاط دور دست بدن گسترش نیافته است.
مرحله 2
تومور در یک محل نامطلوب شروع شده است:
- مثانه یا پروستات
- یک دست یا پا
- محل پارامننژیال (ناحیه ای در کنار غشاهای پوشاننده مغز، مانند مجرای بینی و سینوسهای مجاور، گوش میانی، یا بالاترین قسمت گلو)
- هر قسمت دیگری از بدن که در مرحله 1 ذکر نشده باشد.
عرض تومور بیش از 5 سانتی متر (حدود 2 اینچ) نیست و هیچ مدرکی مبنی بر گسترش آن به غدد لنفاوی مجاور یا نقاط دور دست بدن وجود ندارد.
مرحله 3
تومور در یک محل نامطلوب شروع شده است:
- مثانه یا پروستات
- یک دست یا پا
- محل پارامننژیال (ناحیه ای در کنار غشاهای پوشاننده مغز، مانند مجرای بینی و سینوسهای مجاور، گوش میانی، یا بالاترین قسمت گلو)
- هر قسمت دیگری از بدن که در مرحله 1 ذکر نشده باشد
و یکی از موارد زیر اعمال میشود:
- عرض تومور بیش از 5 سانتی متر نیست اما به غدد لنفاوی مجاور گسترش یافته است
- قطر تومور بزرگتر از 5 سانتی متر است و ممکن است به غدد لنفاوی مجاور سرایت کرده باشد یا نکرده باشد.
در هر دو مورد، سرطان به نقاط دور دست بدن گسترش نیافته است.
مرحله 4
تومور میتواند در هر جایی از بدن شروع شده باشد و میتواند به هر اندازه ای باشد. به قسمتهای دور بدن مانند ریهها، کبد، استخوانها یا مغز استخوان گسترش یافته است.
گروه بالینی
گروه بالینی بر اساس وسعت بیماری و نحوه حذف کامل آن در طی جراحی اولیه است. گروهها به صورت زیر تعریف میشوند:
گروه I
این گروه شامل کودکان مبتلا به RMS موضعی است (سرطان به غدد لنفاوی مجاور یا نقاط دور تر بدن گسترش نیافته است) که با جراحی به طور کامل برداشته میشود.
گروه II
این گروه شامل کودکان مبتلا به RMS موضعی است اما در آنها سلولهای سرطانی در لبههای (حاشیه) نمونه برداشته شده یافت شده است (به این معنی که ممکن است مقدار کمی سرطان باقی مانده باشد).
همچنین شامل کودکان مبتلا به RMS است که به غدد لنفاوی مجاور گسترش یافته است.
گروه III
این کودکان دارای تومورهایی هستند که نمیتوان آنها را به طور کامل برداشت. مقداری تومور باقی مانده بود که با چشم غیر مسلح قابل مشاهده بود. سرطان ممکن است به غدد لنفاوی مجاور سرایت کرده باشد اما هیچ نشانه ای از گسترش آن به اندامهای دور دست وجود ندارد.
گروه IV
در زمان تشخیص، این کودکان شواهدی از گسترش سرطان دور به مکانهایی مانند ریهها، کبد، استخوانها، مغز استخوان یا ماهیچهها یا غدد لنفاوی دوردست دارند.
گروههای خطر
پزشکان با استفاده از اطلاعات مربوط به مرحله TNM، گروه بالینی و وضعیت ژن همجوشی PAX/FOX01، بیماران را به 3 گروه خطر تقسیم میکنند. این به پزشکان کمک میکند تا تصمیم بگیرند که روش درمان در چه حد باید تهاجمی باشد.
گروههای خطر بر اساس آنچه از تحقیقات بر روی افرادی که قبلاً برای RMS درمان شده اند به دست آمده است. گروههایی که در اینجا مورد بحث قرار میگیرند بر اساس جدیدترین اطلاعات هستند اما ممکن است در آینده با توسعه درمانهای ایمنتر و مؤثرتر تغییر کنند.
گروه کم خطر
از هر 3 کودک مبتلا به RMS یک نفر در گروه کم خطر قرار میگیرد. این گروه شامل:
- کودکان مبتلا به RMS مرحله 1 TNM که در گروههای بالینی I، II یا III قرار میگیرد و در آنها سلولهای سرطانی ژن همجوشی PAX/FOX01 ندارند.
- کودکان مبتلا به مرحله 2 یا 3 RMS که در گروههای بالینی I یا II هستند و در آنها سلولهای سرطانی ژن همجوشی PAX/FOX01 ندارند.
گروه با ریسک متوسط
حدود نیمی از کودکان مبتلا به RMS در گروه با خطر متوسط قرار میگیرند. این گروه شامل:
- کودکان مبتلا به مرحله 2 یا 3 RMS که در گروه بالینی III قرار دارند و در آنها سلولهای سرطانی ژن همجوشی PAX/FOX01 ندارند.
- کودکان مبتلا به RMS که به نقاط دور تر بدن گسترش نیافته است (مرحله 1، 2 یا 3) و در آنها سلولهای سرطانی دارای ژن همجوشی PAX/FOX01 هستند.
- کودکان کمتر از 10 سال با RMS گسترده (مرحله 4) که در آن سلولهای سرطانی ژن همجوشی PAX/FOX01 ندارند.
گروه پرخطر
این گروه شامل:
- کودکان 10 ساله یا بزرگتر با RMS گسترده (مرحله 4) که در آن سلولهای سرطانی ژن همجوشی PAX/FOX01 ندارند.
- کودکان مبتلا به RMS گسترده (مرحله 4) که در آن سلولهای سرطانی دارای ژن همجوشی PAX/FOX01 هستند.
میزان بقا برای رابدومیوسارکوم بر اساس گروه خطر
میزان بقا میتواند به شما ایده دهد که چند درصد از افرادی که در موقعیت مشابهی قرار دارند (مثلاً با همان نوع و مرحله سرطان) تا مدت معینی پس از تشخیص هنوز زنده هستند. آنها نمیتوانند دقیقاً به شما بگویند که برای هر فردی چه اتفاقی خواهد افتاد اما ممکن است به شما کمک کنند تا درک بهتری در مورد احتمال موفقیت روند درمان خود پیدا کنید.
نرخ بقا چیست؟
آمارهای مربوط به چشم انداز افراد مبتلا به سرطان اغلب به عنوان نرخ بقا ارائه میشود. میزان بقا درصد افرادی است که حداقل مدت زمان مشخصی (معمولاً 5 سال) پس از تشخیص سرطان زندگی میکنند. به عنوان مثال، نرخ بقای 5 ساله 70 درصد به این معنی است که تخمین زده میشود که 70 نفر از 100 نفری که به آن سرطان مبتلا هستند، 5 سال پس از تشخیص هنوز زنده هستند. البته، بسیاری از مردم بسیار بیشتر از 5 سال زندگی میکنند (و بسیاری از آنها درمان میشوند).
اما به خاطر داشته باشید که میزان بقا تخمینی است و آنها نمیتوانند پیش بینی کنند که در مورد هر فردی چه اتفاقی خواهد افتاد. دیدگاه هر فرد میتواند بر اساس تعدادی از عوامل خاص خود متفاوت باشد. تیم مراقبت از سرطانتان میتواند به شما بگوید که چگونه اعداد زیر ممکن است اعمال شوند زیرا آنها با وضعیت خاص (کودک) شما آشنا هستند.
میزان بقا برای رابدومیوسارکوم
برای یک فرد مبتلا به RMS، گروه خطر در تخمین چشم انداز آنها مهم است اما عوامل دیگری نیز میتوانند بر دیدگاه افراد تأثیر بگذارند، مانند سن و میزان پاسخ سرطان به درمان.
به عنوان مثال، بقای کلی 5 ساله برای کودکان مبتلا به RMS حدود 70 درصد است، در حالی که بقا در بزرگسالان کمتر است.
در اینجا آمار کلی بقا بر اساس گروههای خطر وجود دارد. این اعداد از آزمایشهای بالینی گذشته برای درمان کودکان مبتلا به RMS آمده است.
گروه کم خطر
به طور کلی، نرخ بقای کودکان در گروه کم خطر از حدود 70 درصد تا بیش از 90 درصد متغیر است. این میزان بر اساس محل تومور، مرحله و عوامل دیگر متفاوت است. اکثر این کودکان درمان خواهند شد.
گروه با ریسک متوسط
برای افرادی که در گروه با خطر متوسط قرار دارند، میزان بقا از حدود 50 درصد تا حدود 70 درصد متغیر است. این میزان بر اساس محل تومور، مرحله و سن کودک متفاوت است. (کودکان 1 تا 9 ساله نسبت به کودکان بزرگتر یا کوچکتر عملکرد بهتری دارند.)
گروه پرخطر
میزان بقا در این گروه عموماً حدود 20 تا 30 درصد است. مجدداً، توجه به این نکته مهم است که عوامل دیگری مانند سن بیمار و محل و نوع تومور میتوانند بر این اعداد تأثیر بگذارند. به عنوان مثال، کودکان مبتلا به رابدومیوسارکوم جنینی (ERMS) و گسترش محدود (فقط در 1 یا 2 محل دور) نرخ بقای 5 ساله بالاتری دارند. همچنین، کودکان 1 تا 9 ساله نسبت به بیماران کوچکتر یا بزرگتر چشم انداز بهتری دارند.
حتی با در نظر گرفتن گروههای خطر و سایر عوامل، نرخ بقا در بهترین حالت تخمینهای تقریبی است. تیم مراقبت از سرطان شما بهترین منبع اطلاعاتی شما در مورد این موضوع است زیرا آنها وضعیت شما را بهتر میدانند.
درمان رابدومیوسارکوم
اگر شما یا فرزندتان مبتلا به رابدومیوسارکوم (RMS) تشخیص داده شده باشد، تیم درمانی شما در مورد گزینهها با شما صحبت خواهد کرد. مهم است که مزایای هر گزینه درمانی را در مقابل خطرات و عوارض جانبی احتمالی سنجید.
رابدومیوسارکوم چگونه درمان میشود؟
انواع درمان مورد استفاده برای رابدومیوسارکوم (RMS) عبارتند از:
جراحی (Surgery) برای رابدومیوسارکوم
جراحی بخش مهمی از درمان رابدومیوسارکوم است. اکثر افراد مبتلا به RMS دو نوع جراحی را انجام میدهند:
- بیوپسی برای تشخیص سرطان
- درمان جراحی برای برداشتن تومور(ها)
جراحی بیوپسی (Biopsy surgery)
اگر مشکوک به RMS باشید، بیوپسی لازم است تا مطمئن شوید که به این بیماری مبتلا هستید. نوع بیوپسی مورد نیاز به نتایج آزمایشات تصویر برداری، محل و اندازه تومور، سن و سلامت بیمار و تخصص پزشک بستگی دارد. نحوه انجام بیوپسی میتواند بر دوره درمان بعدی تأثیر بگذارد، بنابراین مهم است که بیوپسی توسط یک پزشک با تجربه در تشخیص و درمان RMS انجام شود. برای کسب اطلاعات بیشتر در مورد بیوپسی، به مبحث آزمایشات رابدومیوسارکوم مراجعه کنید.
جراحی برای برداشتن تومور
اگر مشخص باشد که سرطان به نقاط دور دست بدن گسترش یافته است، جراحی معمولا اولین قدم در درمان RMS است. رزکسیون کامل (برداشتن) تومور اصلی، همراه با برخی از بافتهای طبیعی اطراف، هدف مهم در هر زمان ممکن است. اگر سلولهای سرطانی در لبهها (حاشیه) نمونه برداشته شده وجود داشته باشد (به این معنی که ممکن است برخی از سلولهای سرطانی باقی مانده باشند)، جراح ممکن است دوباره بیمار را عمل کند تا سرطان باقی مانده را حذف کند.
در برخی موارد، جراحی ممکن است انجام شود، حتی اگر مشخص باشد که تمام سرطان قابل برداشتن نیست زیرا ممکن است همچنان به درمانهای دیگر (شیمی درمانی و پرتو درمانی) کمک کند تا بهتر عمل کنند.
در طی جراحی، غدد لنفاوی مجاور ممکن است بیوپسی شوند تا مشخص شود که آیا سرطان به این نواحی گسترش یافته است، به خصوص اگر:
- تومور اصلی در نزدیکی بیضه در پسری 10 ساله یا بیشتر است.
- تومور اصلی روی دست یا پا است.
برخی از انواع جراحی ممکن است نیاز باشد که توسط جراحان خاص انجام شود. برای مثال، برداشتن تومورها در ناحیه سر و گردن ممکن است به تیمهای جراحی با جراحان گوش، حلق و بینی، جراحان پلاستیک، جراحان فک و صورت و جراحان مغز و اعصاب نیاز داشته باشد.
اگر تومور بزرگ باشد یا در نقطهای باشد که برداشتن کامل آن به شدت بر ظاهر بیمار تأثیر بگذارد یا مشکلات دیگری ایجاد کند، ممکن است جراحی تا پس از شیمی درمانی و احتمالاً پرتو درمانی برای کوچک کردن آن به تعویق بیفتد یا ممکن است همه جراحی در این زمان انجام نشود (و تابش به جای آن استفاده خواهد شد).
با انجام جراحی چه انتظاری باید داشت
نوع و وسعت جراحی بسته به محل و اندازه تومور میتواند بسیار متفاوت باشد. RMS میتواند در بسیاری از قسمتهای بدن ظاهر شود، بنابراین نمیتوان در اینجا همه انواع مختلف عملهایی را که ممکن است انجام شود، توصیف کرد. تیم جراحی در مورد جراحی برنامه ریزی شده با شما صحبت میکند اما مطمئن شوید که اگر قسمتهایی از آن برای شما واضح نیست، سؤال کنید.
اگر تشخیص RMS با بیوپسی قبل از عمل اصلی تایید نشد، جراح ممکن است ابتدا فقط یک نمونه کوچک از تومور را بگیرد. نمونه بلافاصله بررسی میشود تا ببینیم سرطانی است یا خیر. اگر در حالی که جراحی هنوز ادامه دارد، بتوان تشخیص داد که سرطان است، جراح ممکن است سعی کند کل تومور را بردارد و همچنین برخی از غدد لنفاوی مجاور را برای بررسی گسترش سرطان از بین ببرد. اگر جراح مشکوک باشد که بیماری به قسمت دیگری از بدن سرایت کرده است، ممکن است قسمتی از تومور متاستاتیک احتمالی برداشته و بررسی شود.
آسپیراسیون مغز استخوان و بیوپسی نیز ممکن است در طول جراحی انجام شود و یک کاتتر ورید مرکزی یا central venous catheter (یک لوله نازک) ممکن است در یکی از وریدهای بزرگ قفسه سینه قرار داده شود. یک انتهای کاتتر در ورید میماند، در حالی که انتهای دیگر درست در زیر یا بیرون پوست قرار دارد.
این میتواند به تیم مراقبتهای بهداشتی کمک کند تا داروهای شیمی درمانی و سایر داروها را تجویز کنند و بدون نیاز به چسباندن سوزن در رگها هر بار نمونه خون بگیرند. کاتتر معمولاً برای چندین ماه در جای خود باقی میماند و میتواند شیمی درمانی را کمتر دردناک کند. اگر چنین وسیله ای در بدن شما قرار داده شود، تیم مراقبتهای بهداشتی به شما یاد میدهد که چگونه از آن مراقبت کنید تا خطر مشکلاتی مانند عفونت را کاهش دهید.
خطرات و عوارض جانبی احتمالی
خطرات و عوارض جانبی کوتاه مدت: بسته به محل تومور، جراحی RMS میتواند یک عمل طولانی و پیچیده باشد. عوارض جانبی جدی کوتاه مدت رایج نیستند اما میتوانند شامل واکنش به بیهوشی، خونریزی بیش از حد، لخته شدن خون و عفونت باشند. درد بعد از عمل شایع است و بیمار ممکن است برای مدتی پس از جراحی با بهبود محل به داروهای مسکن قوی نیاز داشته باشد.
عوارض جانبی طولانی مدت: عوارض جانبی طولانی مدت جراحی عمدتاً به محل تومور و نوع عمل بستگی دارد. تغییرات فیزیکی پس از جراحی میتواند از کمی بیشتر از یک اسکار (جای زخم) تا تغییرات ظاهری یا نحوه عملکرد برخی از قسمتهای بدن متغیر باشد که ممکن است به توانب خشی فیزیکی نیاز داشته باشد.
شیمی درمانی (Chemotherapy) برای رابدومیوسارکوما
شیمی درمانی (chemo) استفاده از داروها برای درمان سرطان است. شیمی درمانی یک درمان سیستمیک است، به این معنی که داروها وارد جریان خون میشوند و در سراسر بدن میروند تا سلولهای سرطانی را از بین ببرند. این امر شیمی درمانی را برای کشتن سلولهای سرطانی که به سایر قسمتهای بدن گسترش یافته اند، مفید میکند، حتی اگر دیده نشوند.
شیمی درمانی بخش مهمی از درمان رابدومیوسارکوم (RMS) است. حتی اگر به نظر برسد که تمام سرطان با جراحی برداشته شده است، بدون شیمی درمانی احتمال بازگشت آن وجود دارد.
پس از جراحی، رسوبات ریز RMS که هنوز در بدن هستند، اغلب میتوانند توسط شیمی درمانی از بین بروند. اگر بعد از جراحی مناطق بزرگتری از تومور باقی بماند (یا اگر جراحی به دلایلی انجام نشود)، شیمی درمانی (همراه با پرتو درمانی) اغلب میتواند این نواحی را کوچک کند. در برخی موارد ممکن است به اندازه کافی تومور را کوچک کند که جراحی بتواند تومور باقی مانده را به طور کامل حذف کند.
داروهای شیمی درمانی که برای درمان رابدومیوسارکوم استفاده میشود
پزشکان شیمی درمانی را به صورت چرخه ای انجام میدهند که معمولاً 1 یا 2 روز متوالی درمان انجام میشود و به دنبال آن چند روز به بدن زمان میدهند تا بهبود یابد. برای RMS، شیمی درمانی معمولاً یک بار در هفته برای چند ماه اول و سپس کمتر انجام میشود. طول کلی دوره درمان معمولا از 6 ماه تا یک سال متغیر است.
برخی از داروها را میتوان از طریق دهان مصرف کرد اما بیشتر آنها به صورت IV (تزریق داخل رگ) تجویز میشوند.
ترکیبی از داروهای شیمی درمانی برای درمان بیماران مبتلا به RMS استفاده میشود. اینکه کدام داروها استفاده میشوند اغلب به این بستگی دارد که بیمار در کدام گروه خطر قرار دارد.
برای افراد در گروه کم خطر، ترکیبات اصلی داروهای مورد استفاده عبارتند از:
- VA: وین کریستین (vincristine) و داکتینومایسین (dactinomycin، همچنین به عنوان اکتینومایسین-D شناخته میشود)
- VAC: وین کریستین، داکتینومایسین و سیکلوفسفامید (cyclophosphamide)
برای گروه در معرض خطر متوسط، رایج ترین رژیمها عبارتند از:
- VAC: وین کریستین، داکتینومایسین و سیکلوفسفامید
- VAC/VI: وین کریستین، داکتینومایسین، و سیکلوفسفامید، متناوب با وین کریستین و ایرینوتکان (irinotecan)
پزشکان همچنین در حال بررسی هستند که آیا افزودن داروی هدفمند تمسیرولیموس (temsirolimus) به رژیم VAC/VI ممکن است به عملکرد بهتر آن کمک کند یا خیر.
برای افرادی که در گروه پرخطر قرار دارند (شامل آنهایی که بیماری متاستاتیک دارند)، رژیم VAC رایج ترین مورد استفاده است. از آن جایی که درمان این سرطانها سخت است، پزشکان استفاده از شیمی درمانی شدیدتر را که شامل چندین داروی دیگر (مانند دوکسوروبیسین، ایفوسفامید و اتوپوزید) نیز میشود، مطالعه کرده اند.
روش دیگری که مورد مطالعه قرار گرفته است، دادن دوزهای بالاتر شیمی درمانی است که گاهی اوقات با پیوند سلولهای بنیادی دنبال میشود اما تا کنون مشخص نیست که هر یک از این رویکردها بهتر از شیمی درمانی استاندارد هستند و میتوانند عوارض جانبی بیشتری ایجاد کنند.
اکثر پزشکان توصیه میکنند که افراد در گروه پرخطر در یک کارآزمایی بالینی تحت درمان با داروهای جدید و ترکیبات دارویی قرار گیرند. امید است که داروهای جدیدتر به افرادی که در گروه پرخطر هستند کمک کنند تا عمر طولانی تری داشته باشند.
عوارض جانبی احتمالی
داروهای شیمی درمانی میتوانند سلولهای دیگری غیر از سلولهای سرطانی را تحت تأثیر قرار دهند که همین امر میتواند منجر به عوارض جانبی شود. عوارض جانبی به نوع و دوز داروها و مدت زمان تجویز آنها بستگی دارد.
کودکان نسبت به بزرگسالان عوارض جانبی کمتری از شیمی درمانی دارند و اغلب سریعتر از عوارض جانبی بهبود مییابند. به همین دلیل است که پزشکان اغلب میتوانند دوزهای بالاتری از شیمی درمانی برای کشتن تومور به آنها بدهند.
عوارض جانبی عمومی: عوارض جانبی رایج در بسیاری از داروهای شیمی درمانی عبارتند از:
- ریزش مو
- زخمهای دهانی
- از دست دادن اشتها
- تهوع و استفراغ
- اسهال
- افزایش احتمال عفونت (به دلیل داشتن گلبولهای سفید بسیار کم)
- کبودی یا خونریزی آسان (به دلیل داشتن تعداد بسیار کم پلاکت خون)
- خستگی (به دلیل داشتن گلبولهای قرمز بسیار کم)
بیشتر این عوارض پس از پایان دوره درمان از بین میروند. اغلب راههایی برای کاهش این عوارض وجود دارد.
به عنوان مثال، داروهایی برای کمک به پیشگیری یا کاهش تهوع و استفراغ تجویز میشود. حتماً از پزشک یا پرستار خود در مورد داروهایی که به کاهش عوارض جانبی کمک میکند بپرسید و هر گونه عوارض جانبی را در فرزندتان گزارش دهید تا بتوان آنها را به طور مؤثر مدیریت کرد.
عوارض جانبی برخی داروها: همراه با خطرات فوق، برخی از داروهای شیمی درمانی میتوانند عوارض جانبی خاصی داشته باشند (اگرچه این موارد نسبتاً غیر معمول هستند). مثلا:
- سیکلوفسفامید و ایفوسفامید میتوانند به مثانه آسیب برسانند و باعث ایجاد خون در ادرار شوند. خطر این اتفاق را میتوان با دادن مایعات فراوان و دارویی به نام مسنا (mesna) که به محافظت از مثانه کمک میکند، کاهش داد.
- وین کریستین میتواند به اعصاب آسیب برساند. برخی از بیماران ممکن است متوجه گزگز و بی حسی (به نام نوروپاتی یا neuropathy) شوند، به ویژه در دستها و پاها. این عارضه اغلب پس از قطع درمان از بین میرود یا بهتر میشود اما در برخی افراد ممکن است به مدت طولانی ادامه داشته باشد.
- برخی از داروها همچنین میتوانند به تخمدانها یا بیضهها آسیب برسانند که ممکن است بر باروری (توانایی بچه دار شدن) در مراحل بعدی زندگی تأثیر بگذارد. با تیم مراقبت از سرطان در مورد خطرات ناباروری با درمان صحبت کنید و بپرسید که آیا گزینههایی برای حفظ باروری وجود دارد، مانند بانک اسپرم یا بانک بافت تخمدان.
- برخی از داروهای شیمی درمانی نیز میتوانند خطر ابتلا به نوع دوم سرطان را که معمولاً نوعی سرطان خون است، در سالها پس از درمان RMS افزایش دهند. اما این نادر است و اهمیت شیمی درمانی در درمان RMS بسیار بیشتر از این خطر است.
پرتو درمانی (Radiation Therapy) برای رابدومیوسارکوم
پرتو درمانی از پرتوهای پرانرژی برای از بین بردن سلولهای سرطانی استفاده میکند. این اغلب یک راه موثر برای از بین بردن سلولهای سرطانی است که با جراحی قابل برداشتن نیستند. هنگامی که پرتو درمانی برای کمک به درمان رابدومیوسارکوم (RMS) استفاده میشود، معمولاً همراه با شیمی درمانی دنبال میشود.
چه زمانی میتوان از پرتو درمانی استفاده کرد؟
پرتو درمانی اغلب زمانی مورد استفاده قرار میگیرد که برخی از تومورهای اصلی هنوز پس از جراحی باقی مانده باشند (گروه بالینی II یا III) یا اگر برداشتن کامل تومور به معنای از دست دادن یک عضو مهم مانند چشم یا مثانه باشد یا باعث تغییر شکل شود. معمولاً برای کودکان مبتلا به رابدومیوسارکوم جنینی (ERMS) که میتوان آن را به طور کامل با جراحی برداشت (گروه بالینی I) مورد نیاز نیست.
معمولاً پرتو درمانی پس از 6 تا 12 هفته از شیمی درمانی به هر ناحیه از بیماری باقی مانده داده میشود. یک استثنا زمانی است که یک تومور در نزدیکی مننژها (پوششهای مغز) به استخوانهای جمجمه، خود مغز یا به نخاع رشد کرده باشد. به این بیماران معمولاً بلافاصله پرتو درمانی (همراه با شیمی درمانی) داده میشود.
اگر سرطان به قسمت دیگری از بدن گسترش یافته باشد، ممکن است به مناطق خاصی از گسترش سرطان شناخته شده اشعه داده شود تا علائم ایجاد شده کاهش یابد.
نحوه انجام پرتو درمانی
این نوع درمان توسط دکتری به نام انکولوژیست رادیواکتیو انجام میشود. قبل از شروع درمان، تیم پرتو درمانی با آزمایشهای تصویر برداری مانند اسکنهای MRI اندازه گیریهای دقیقی انجام میدهد تا زوایای صحیح برای نشانه گیری پرتوها و دوز مناسب تابش را تعیین کند. این جلسه برنامه ریزی شبیه سازی (simulation) نامیده میشود. همچنین ممکن است برای بیماران یک قالب پلاستیکی شبیه قالب بدن تعبیه شود تا هر بار آنها را در همان موقعیت نگه دارد تا بتوان پرتوها را با دقت بیشتری هدف قرار داد.
تابش معمولاً 5 روز در هفته برای چندین هفته انجام میشود. هر جلسه درمانی بسیار شبیه به عکس گرفتن با اشعه ایکس است، اگرچه دوز تابش بسیار قوی تر است. در هر جلسه، بیمار روی یک میز مخصوص دراز میکشد در حالی که دستگاه پرتو را از زوایای دقیق ارسال میکند. روند درمان دردناک نیست.
هر جلسه حدود 15 تا 30 دقیقه طول میکشد و بیشتر زمان صرف اطمینان از هدف گیری صحیح پرتو میشود. زمان واقعی جلسه درمانی هر روزه بسیار کوتاهتر است. ممکن است به برخی از کودکان کوچکتر قبل از هر جلسه دارویی داده شود تا آنها را بخواباند تا در طول درمان حرکت نکنند.
انواع پرتو درمانی
تکنیکهای پرتو درمانی مدرن به پزشکان کمک میکنند تا درمان تومور را با دقت بیشتری نسبت به گذشته انجام دهند.
پرتو درمانی سه بعدی منسجم (3D-CRT): 3D-CRT از نتایج آزمایشهای تصویر برداری مانند MRI و رایانههای ویژه برای نقشه برداری دقیق از محل تومور استفاده میکند. سپس پرتوهای تابشی شکل میگیرند و از چندین جهت به سمت تومور نشانه میروند. هر پرتو به تنهایی نسبتا ضعیف است که باعث میشود کمتر به بافتهای طبیعی بدن آسیب برساند اما پرتوها در تومور به هم میرسند تا دوز بالاتری از تابش را در آن جا ایجاد کنند.
پرتو درمانی تعدیل شده با شدت (IMRT یا Intensity-modulated radiation therapy): IMRT شکل پیشرفته ای از درمان سه بعدی است. همراه با شکل دادن به پرتوها و هدف قرار دادن آنها به سمت تومور از چندین زاویه، شدت (قدرت) پرتوها برای محدود کردن دوز رسیدن به حساس ترین بافتهای طبیعی تنظیم میشود. این به پزشکان اجازه میدهد دوز بالاتری را به نواحی سرطانی برسانند. بسیاری از بیمارستانهای بزرگ و مراکز سرطان اکنون از IMRT استفاده میکنند.

براکی تراپی یا Brachytherapy (پرتو درمانی داخلی): روش دیگر قرار دادن منبع رادیواکتیو در داخل یا نزدیک تومور برای مدت کوتاهی است. تشعشع فقط مسافت کوتاهی را طی میکند، بنابراین تومور بیشتر تابش را دریافت میکند.
این رویکرد ممکن است به ویژه در درمان برخی از تومورهای مثانه، واژن و ناحیه سر و گردن مفید باشد. برخی از مطالعات اولیه نشان میدهد که این ممکن است راه خوبی برای حفظ عملکرد این اندامها در بسیاری از کودکان باشد.
عوارض جانبی احتمالی
عوارض جانبی پرتو درمانی به محل هدف پرتو، دوز پرتو و سن فرد بستگی دارد. (کودکان خردسال بسیار بیشتر تحت تأثیر تشعشعات قرار میگیرند.) برخی از عوارض جانبی احتمالاً مدت کوتاهی باقی میمانند، در حالی که برخی دیگر ممکن است طولانی تر باشند.
عوارض جانبی کوتاه مدت میتواند شامل موارد زیر باشد:
- خستگی
- افزایش خطر عفونت
- اثرات روی پوست در مناطقی که تشعشع دریافت میکنند، از ریزش مو و تغییرات خفیف مانند آفتاب سوختگی تا واکنشهای پوستی شدیدتر
- تهوع، استفراغ و اسهال (ناشی از تشعشعات بر روی شکم یا لگن)
- آسیب به مثانه که ممکن است باعث مشکلات ادراری شود (ناشی از تشعشعات بر روی شکم یا لگن)
- زخمهای دهانی و از دست دادن اشتها (ناشی از تابش اشعه به ناحیه سر و گردن)
عوارض جانبی طولانی مدت میتواند جدی تر باشد، به خصوص در کودکان در حال رشد، بنابراین پزشکان سعی میکنند تا حد امکان آنها را محدود کنند.
مغز کودکان کوچک به تشعشع بسیار حساس است، بنابراین پزشکان سعی میکنند تا حد امکان از استفاده از اشعه به سر خودداری کنند. در صورت نیاز، این نواحی با دقت بسیار هدف قرار میگیرند تا میزان رسیدن تابش به مغز محدود شود. عوارض جانبی پرتو درمانی برای مغز میتواند شامل سردرد و مشکلاتی مانند از دست دادن حافظه، تغییرات شخصیتی و مشکلات یادگیری در مدرسه باشد. این مشکلات 1 یا 2 سال پس از درمان جدی تر میشوند.
سایر مشکلات طولانی مدت میتواند شامل تشکیل بافت اسکار (زخم) و کند شدن رشد استخوان در مناطقی باشد که پرتو درمانی میشوند. بسته به سن کودک و قسمتهایی از بدن که تحت تاثیر قرار میگیرند، این میتواند منجر به ناهنجاریها یا عدم رشد کامل قد شود. تشعشعات همچنین میتواند خطر ابتلا به سرطان را در سالها بعد افزایش دهد.
برای محدود کردن خطر عوارض طولانی مدت پرتو، پزشکان از کمترین دوز پرتو درمانی استفاده میکنند که هنوز موثر است.
شیمی درمانی با دوز بالا (High-Dose Chemotherapy) و پیوند سلولهای بنیادی (Stem Cell Transplant) برای رابدومیوسارکوم
پیوند سلولهای بنیادی (گاهی اوقات به عنوان پیوند مغز استخوان یا bone marrow transplant شناخته میشود) استفاده از دوزهای بسیار بالاتر از شیمی درمانی (chemo) را ممکن میسازد.
داروهای شیمی درمانی سلولهای طبیعی را که به سرعت تقسیم میشوند (مانند سلولهای مغز استخوان، جایی که سلولهای خونی جدید ساخته میشوند) و همچنین سلولهای سرطانی را از بین میبرند. دوزهای بالاتر از این داروها ممکن است در درمان برخی سرطانها موثرتر باشند اما نمیتوان آنها را تجویز کرد زیرا آسیب شدید به مغز استخوان باعث کمبود سلولهای خونی که تهدید کننده زندگی است، میشود.
پیوند سلولهای بنیادی میتواند با خارج کردن و ذخیره برخی از سلولهای بنیادی سازنده خون خود بیمار (از خون یا مغز استخوان) قبل از شیمی درمانی با دوز بالا و سپس بازگرداندن آنها به خون پس از پایان شیمی درمانی، این مشکل را برطرف کند. سلولهای بنیادی سپس به مغز استخوان میروند که به مغز استخوان طبیعی اجازه رشد مجدد میدهد.
پیوند سلولهای بنیادی برای درمان برخی از سرطانهای تهاجمی دوران کودکی استفاده میشود اما تا کنون مشخص نیست که آیا میتواند به بیماران رابدومیوسارکوم کمک کند یا خیر. به دلیل عوارض جانبی شدیدی که میتوانند ایجاد کنند، اکثر پزشکان توصیه میکنند که در این زمان فقط به عنوان بخشی از یک کارآزمایی بالینی از آنها استفاده شود.
رویکردهای درمانی رایج
RMS تقریباً همیشه هم با درمان موضعی (جراحی و یا پرتو درمانی) و هم با شیمی درمانی درمان میشود اما جزئیات درمان بر اساس تعدادی از عوامل، از جمله محل و وسعت تومور و اینکه بیمار در کدام گروه خطر قرار میگیرد، میتواند متفاوت باشد.
همه کودکان و بزرگسالان مبتلا به RMS با جراحی برای برداشتن تومور در صورتی که بدون ایجاد آسیب یا تغییر شکل عمده انجام شود، درمان خواهند شد. اگر این امر امکان پذیر نباشد، ممکن است ابتدا از شیمی درمانی و یا پرتو درمانی برای کوچک کردن تومور استفاده شود. اگر تومور به اندازه کافی کوچک شود، میتوان در این مرحله عمل جراحی انجام داد. هدف از جراحی برداشتن کامل تومور است اما این همیشه ممکن نیست.
حتی اگر به نظر میرسد که تومور به طور کامل برداشته شده است، همه بیماران مبتلا به RMS به شیمی درمانی نیاز دارند. بدون آن، بسیار محتمل است که سرطان در نقاط دورتر بدن عود کند زیرا تقریباً همیشه مقادیر کمی از سرطان در هنگام یافتن سرطان به سایر نقاط بدن رسیده است (حتی تصور میشود که این گسترش در آزمایشات تصویر برداری قابل مشاهده نیستند.)
اگر سرطان پس از جراحی باقی بماند یا اگر سرطان دارای برخی از ویژگیهای نامطلوبتر باشد و به نقاط دور سرایت نکرده باشد (همان طور که اغلب اوقات وجود دارد)، پرتو درمانی نیز انجام میشود.
اگر سرطان به رشد خود ادامه دهد یا بعداً عود کند، میتوان از بسیاری از این درمانها دوباره استفاده کرد.
رابدومیوسارکوم که پس از درمان اولیه پیشرفت یا عود میکند
اغلب درمان رابدومیوسارکومی (RMS) که در طول درمان به رشد خود ادامه میدهد یا پس از پایان درمان عود میکند، سخت است. گزینههای درمانی به عوامل مختلفی بستگی دارد، از جمله:
- جایی که سرطان عود میکند.
- نوع RMS
- کدام درمانها قبلاً استفاده شده است.
- سن و سلامت کلی بیمار
برای تومورهایی که در همان نقطه تومور اصلی عود میکنند، در صورت امکان از جراحی استفاده میشود. اگر پرتو درمانی بخشی از درمان اولیه نبود، ممکن است از آن نیز استفاده شود.
در موارد نادر، ممکن است برای سرطانهایی که در سایر قسمتهای بدن عود میکنند، از جراحی استفاده شود، مثلاً اگر عود کوچکی در ریه وجود داشته باشد. در این جا نیز پرتو درمانی ممکن است گزینه دیگری باشد.
در اغلب موارد، شیمی درمانی بهترین گزینه است در صورتی که سرطان به سایر قسمتهای بدن گسترش یافته باشد. این ممکن است شامل برخی از داروهای ذکر شده در شیمی درمانی برای رابدومیوسارکوم و همچنین داروهای جدیدتری باشد که اکنون در حال مطالعه هستند.
از آن جایی که درمان این تومورها اغلب سخت است، شرکت در آزمایشات بالینی درمانهای جدیدتر ممکن است در بسیاری از موارد گزینه خوبی باشد.
چه چیزی در تحقیقات رابدومیوسارکوم جدید است؟
درمان رابدومیوسارکوما (RMS) در چند دهه گذشته راه طولانی را طی کرده است و بیماران بیشتری نسبت به قبل از RMS جان سالم به در میبرند. با این حال، کار بیشتری باید انجام شود. تحقیقات در مورد RMS در بسیاری از مراکز پزشکی، بیمارستانهای دانشگاهی و سایر موسسات در سراسر جهان انجام میشود.
طبقه بندی بهتر رابدومیوسارکوم
تکنیکهای مولکولی جدیدتر به پزشکان کمک میکنند تا RMS را بهتر دسته بندی و پیش بینی کنند که کدام بیماران به درمانهای خاص بهتر پاسخ خواهند داد. به عنوان مثال، به جای مشاهده سلولهای سرطانی در زیر میکروسکوپ، محققان شروع به استفاده از آزمایشهای ژنتیکی ویژه برای کمک به طبقه بندی RMS کرده اند.
تقریباً 1 مورد از هر 4 مورد سرطانی که پزشکان معمولاً آنها را به عنوان رابدومیوسارکوم آلوئولار (ARMS) طبقه بندی میکنند، فاقد تغییر ژنی معمولی (ژن همجوشی PAX/FOXO1) هستند که در ARMS مشاهده میشود. مشخص شده است که این سرطانها بیشتر شبیه رابدومیوسارکوم جنینی (ERMS) عمل میکنند که معمولاً نسبت به ARMS به درمان فشردهتری نیاز دارد. به دلیل این یافته، پزشکان اکنون میتوانند به بیماران مبتلا به این سرطانها درمانهای با شدت کمتری بدهند و همچنان به همان نتایج دست یابند.
بهبود درمانهای استاندارد
هدف اصلی تحقیقات فعلی، درمان موثرتر همه بیماران، در عین حال کاهش نیاز به درمانهای فشرده (و عوارض جانبی آنها) در صورت امکان است. برای مثال، محققان در حال بررسی این موضوع هستند که آیا کودکانی که در معرض خطر کم عود تومور هستند، میتوانند بدون استفاده از درمانهای بالقوه مضر مانند پرتو درمانی درمان شوند.
از آن جایی که بدن کودکان به تشعشع بسیار حساس است، پزشکان به دنبال راههایی برای محدود کردن دوزها تا حد ممکن هستند. روشهای جدیدتر پرتو درمانی به پزشکان اجازه میدهند تا پرتو را با دقت بیشتری هدف گیری کرده و میزان رسیدن به بافتهای طبیعی بدن را محدود کنند. برخی از این تکنیکها در مبحث پرتو درمانی برای رابدومیوسارکوم توضیح داده شده است.
راههای دیگری برای تابش اشعه نیز در حال مطالعه است. به عنوان مثال، در پرتو درمانی بدن استریوتاکتیک (stereotactic body radiation therapy یا SBRT)، یک دستگاه خاص، پرتوهای بسیار نازکی از تشعشع را از زوایای مختلف به سمت تومور هدف قرار میدهد و آن را برای مدت کوتاهی با دقت روی تومور متمرکز میکند.
تابش پرتو پروتون (Proton beam radiation) یکی دیگر از رویکردهای جدیدتر است. پرتوهای تابشی استاندارد هنگام عبور از بدن، در تمام نقاط یکسان تابش میدهند. تابش پرتو پروتون از ذرات رادیواکتیو استفاده میکند که قبل از آزاد شدن بیشتر انرژی خود، فقط مسافت خاصی را طی میکنند. پزشکان میتوانند از این ویژگی برای محدود کردن تابش به بافتهای طبیعی بدن استفاده کنند. این رویکرد امیدوار کننده به نظر میرسد اما هنوز مشخص نیست که آیا بهتر از سایر اشکال جدیدتر پرتو درمانی است یا خیر. همچنین در حال حاضر فقط در تعداد محدودی از مراکز در سراسر آمریکا در دسترس است.

پزشکان همچنین در حال بررسی افزودن داروهای شیمی درمانی جدیدتر مانند ایرینوتکان (irinotecan) و تموزولوماید (temozolomide) به رژیمهای شیمی درمانی استاندارد برای بیمارانی هستند که در معرض خطر بالاتر عود تومور هستند.
برای بیمارانی که در معرض خطر بالای عود تومور قرار دارند، پزشکان به شیمی درمانی بیشتر توجه کرده اند (مانند شیمی درمانی هر 2 هفته به جای هر 3 هفته). این مفهوم فشرده سازی فاصله ای (interval compression) نامیده میشود. اما تا کنون، مشخص نیست که آیا این کار بهتر از ارائه آن در فواصل زمانی استاندارد است یا خیر.
داروهای هدفمند (targeted drugs) جدیدتر و ایمونوتراپی (immunotherapy)
داروهایی که بخشهای خاصی از سلولهای سرطانی را هدف قرار میدهند (برخلاف حمله به سلولهای با رشد سریع، همان طوری که داروهای شیمی درمانی انجام میدهند) اکنون برای استفاده در RMS مورد مطالعه قرار میگیرند. برخی از این داروها در حال حاضر برای درمان برخی سرطانهای بزرگسالان استفاده میشود. نمونههایی از داروهای هدفمند جدیدتری که برای استفاده در برابر RMS مورد مطالعه قرار گرفته اند عبارتند از:
- مهار کنندههای IGF-1R، مانند سیکسوتوموماب (IMC-1A2 یا cixutumumab) و گانیتوماب (ganitumab یا AMG479)
- داروهایی که بر توانایی تومور برای ساخت رگهای خونی جدید تأثیر میگذارند، مانند بواسیزوماب (Avastin)، سورافنیب (Nexavar) و رگورافنیب (Stivarga)
- داروهایی که پروتئین mTOR را هدف قرار میدهند، مانند تمسیرولیموس (Torisel) و everolimus (Afinitor)
- داروهایی که پروتئین ALK را هدف قرار میدهند، مانند کریزوتینیب (Xalkori)
- داروهایی که مسیر سیگنالینگ جوجه تیغی (hedgehog pathway) سلول را هدف قرار میدهند، مانند سونیدگیب (Odomzo)
- داروهایی که سایر پروتئینهای سلولی را هدف قرار میدهند، مانند داساتینیب (Sprycel)
محققان همچنین در حال آزمایش راههایی برای تقویت سیستم ایمنی بدن برای درمان RMS هستند. به عنوان مثال، برخی از محققان به دنبال قرار دادن برخی از سلولهای سیستم ایمنی بدن، به نام سلولهای دندریتیک (dendritic cells)، در معرض پروتئین غیر طبیعی PAX-FOXO1 هستند که در بسیاری از سلولهای ARMS یافت میشود. امید این است که سلولهای دندریتیک باعث شوند که سیستم ایمنی به این سلولها بدون توجه به جایی که در بدن هستند، حمله کند.
در نهایت، ترکیبی از این رویکردها ممکن است بهترین راه برای درمان RMS باشد.
همچنین بخوانید:
- تومور ویلمز چیست؟ انواع، علائم، درمان
- سرطان پوست سلول بازال و سنگفرشی چیست؟ علائم، تشخیص و درمان
- نوروبلاستوما (Neuroblastoma) چیست؟ علائم، تشخیص، پیشگیری و درمان
- سارکوم بافت نرم چیست؟ انواع، علائم، تشخیص و درمان
- استئوسارکوم (Osteosarcoma) چیست؟ علائم، تشخیص، پیشگیری و درمان
مترجم: فاطمه فریادرس






آیا سرطان رابدومیوسارکم تهاجمی است اگر باشد از نوع گرید چند است؟؟؟
رابدومیوسارکوما به طور کلی به عنوان یک تومور بسیار تهاجمی شناخته میشود، به این معنا که این بیماری میتواند به سرعت رشد کند و به بافتهای مجاور و حتی به دیگر نقاط بدن سرایت کند (متاستاز). این سرطان در درجههای مختلف تهاجمی میتواند دستهبندی شود که شامل پارامترهایی مانند اندازه تومور، محل تومور، و ویژگیهای سلولی تومور است.